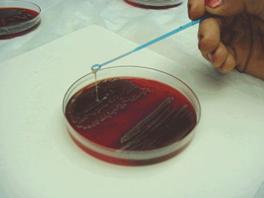
克雷伯氏菌感染

簡要介紹
 克雷伯氏菌
克雷伯氏菌病原學
 肺炎克雷伯氏菌
肺炎克雷伯氏菌克雷伯氏菌屬(Klebsiella)為革蘭氏陰性桿菌。主要有肺炎克雷伯氏菌(K.peneumoniae)、臭鼻克雷伯氏菌(K.ozaenae)和鼻硬結克雷伯氏菌(K.rhinoscleromatis)。其中肺炎克雷伯氏菌對人致病性較強,是重要的條件致病菌和醫源性感染菌之一。
一、生物學性狀
為較短粗的桿菌,大小0.5~0.8×1~2um,單獨、成雙或短鏈狀排列。無芽胞,無鞭毛,有較厚的莢膜,多數有菌毛。
營養要求不高,有普通瓊脂培養基上形成較大的灰白色粘液菌落,以接種環挑之,易拉成絲,有助鑑別。在腸道桿菌選擇性培養基上能發酵乳糖,呈現有色菌落。
具有O抗原與K抗原,後者用以分型。利用莢膜腫脹試驗,本屬K抗原可82型。肺炎克氏菌屬3型和12型;臭鼻克氏菌主要屬4型,少數為5型或6型;鼻硬結克氏菌一般屬3型,但並非所有3型均為該菌。
本屬細菌55℃30分鐘被殺死。在培養基上可存活數周至數月。
二、病症性
克雷伯氏菌
克雷伯氏菌(一)肺炎克雷伯氏菌
1882年Friedlander首先從大葉性肺炎痰液中分離出,故也稱為Friedlander桿菌,簡稱肺炎桿菌。該菌產生胞外毒性複合物(extracellulartoxiccomplex,ETC),主要成分為莢膜多糖(63%)、脂多糖(30%)和少量蛋白質(7%)。有些菌株還可產生LT和ST腸毒素。莢膜也與致病力有關。
本菌存在於人體腸道、呼吸道。可引起支氣管炎、肺炎,泌尿系和創傷感染,甚至敗血症、腦膜炎、腹膜炎等。
(二)臭鼻克雷伯氏菌
簡稱臭鼻桿菌,引起慢性萎縮性鼻炎,有惡臭,以及敗血症、泌尿系感染等。
(三)鼻硬結克雷伯氏菌
簡稱鼻硬結桿菌,引起慢性肉芽腫性病變,侵犯鼻咽部,使組織發生壞死。
易感情況
 治療克雷伯氏菌感染的藥物
治療克雷伯氏菌感染的藥物①各種降低免疫功能的慢性病,如慢性支氣管炎、肝硬變、糖尿病和惡性腫瘤等。
②腎上腺皮質激素和其他免疫抑制劑的套用。
③廣譜抗生素的使用致正常菌群變化。
④各種器械操作和創傷性診療技術(如各種導管、氣管切開等,為細菌入侵創造了條件)。
病理變化
 治療用藥
治療用藥臨床表現
 化膿性腦膜炎
化膿性腦膜炎診斷方法
急性肺炎伴嚴重中毒症狀和棕紅色膠凍痰,痰塗片發現大量帶莢膜的革蘭氏陰性桿菌或2次以上痰培養獲肺炎桿菌,即可確診肺炎桿菌肺炎。敗血症的確診有賴於血液中檢出肺炎桿菌,宜在抗菌治療前或寒戰、高熱時抽出血液作培養。受累組織器官的膿液或分泌物發現或培養出本菌可確診本菌肺外感染。
治療方法
抗生素的選擇應根據臨床感染的嚴重程度而定。大多數肺炎桿菌對慶大黴素等氨基糖苷類抗生素、頭孢菌素類諸如頭孢唑啉和頭孢呋肟(西力欣)、氧哌嗪青黴素較敏感,氯黴素及多粘菌素亦有一定療效。嚴重病例多主張用第二代或第三代頭孢菌素+慶大黴素或丁胺卡那黴素,或頭孢菌素+氧哌嗪青黴素聯合治療,療程至少2周。若有膿胸、化膿性腦膜炎等應及時穿刺排膿,並在全身抗菌治療的基礎上局部套用適當的抗生素。此外,必須積極治療基礎病和併發症,消除可削弱機體免疫功能的因素。加強支持療法如供給足夠熱量,維持水、電解能平衡等均不可忽視。
克雷伯氏菌的鑑別
 治療用藥
治療用藥狐狸肺炎克雷伯氏菌病
 狐狸
狐狸該養殖場引進狐狸10組,共50隻,3天后發病,開始僅表現精神沉鬱、食慾減退,畜主立即使用青、鏈黴素進行注射治療,但效果不明顯。2天后有3隻死亡,其他病情在逐漸加重。病畜臨床表現被毛逆亂,體溫升高,結膜蒼白,呼吸淺速,偶爾咳嗽,鼻腔有分泌物,站立不穩。
剖檢變化
病死狐狸剖檢主要表現上呼吸道黏膜充血水腫,肺出血、充血、氣腫;慢性病畜剖檢主要表現在化膿性胸膜炎,胸腔內有炎性分泌物,頸淋巴結、腎、肝膿腫,肺“肉芽腫性”實變,肺膨脹不全、表面有灰白色小結節。
細菌分離
取肝組織和胸腔內分泌物分別接種普通營養瓊脂、S.S.瓊脂、血瓊脂、肉湯和厭氧肉湯,37℃培養24h,結果普通營養瓊脂和血瓊脂上長出灰白色黏稠菌落,以接種環挑之,易拉成絲;S.S.上不生長;肉湯和厭氧肉湯均混濁,並大量產氣。取平皿上和肉湯中的培養物塗片,革蘭氏染色,為陰性短桿菌,兩端較鈍,並濃染,呈單個、成對和短鏈狀排列。
生化試驗
(1)取平皿上生長的白色、黏稠、光滑單個菌落接種三糖鐵斜面,結果斜面和底層產酸,底層產氣,不產生硫化氫。(2)將純培養的細菌經ATBExpression自動細菌鑑定分析儀測定,採用ID32GN生化鑑定條,結果該菌為克雷伯氏菌肺炎亞種。
動物實驗
以該菌純培養的肉湯培養液0.2ml腹腔接種15g左右小鼠5隻,均於24h內死亡,從心血和內臟中分離到該菌。
藥敏試驗
按常規紙片法進行。高敏藥有頭孢氨苄、卡那黴素、新黴素和慶大黴素;中敏藥有鏈黴素、痢特靈和強力黴素;不敏感藥有磺胺嘧啶、乙醯螺鏇黴素、氨苄青黴素和阿莫西林。
治療
淘汰病情特別嚴重、無治療意義的狐狸;對病情減輕的採取頭孢氨苄輸液、新黴素拌料治療;對少食、發燒、呼吸困難的病畜進行對症治療;加強狐狸舍的環境衛生,用過氧乙酸進行環境和帶畜消毒;加強飼料管理,狐狸舍要陽光充足,通風保暖,防止受寒及賊風侵襲。經過10天的治療,病情得到控制,狐狸群恢復正常。
小結與討論
(1)根據發病情況、臨床症狀、剖檢變化,結合細菌的分離鑑定和動物實驗,確診該病是由肺炎克雷伯氏菌感染引起的。
(2)肺炎克雷伯氏菌廣泛分布於自然界如土壤、水和農產品及林產品中,在人和動物的腸道及呼吸道內也常見,是典型的條件致病菌,常於動物抵抗力下降時引起暴發性流行。該養殖場狐狸肺炎克雷伯氏菌病的暴發正是由於狐狸在運輸過程中受到應激,抵抗力下降,體內的病菌大量繁殖而造成的;再加上畜主養殖經驗缺乏,未對引進的狐狸加強飼養管理和進行藥物預防,從而加重了狐狸的病情。
(3)近年來雖然中國養殖業,尤其是經濟動物養殖業得到了迅猛發展,但養殖戶的管理水平並沒有得到相應的提高,無論從養殖場的硬體方面還是軟體方面,都沒有進行規範化管理,平常無病不免疫,有病亂投醫、亂治療,造成養殖場內疫病不斷,很難除根。近年來由於感染因素的改變,人和動物感染的菌譜也發生了較大變化,總的趨勢是革蘭氏陽性球菌的感染在逐漸減少,而由革蘭氏陰性桿菌引起的感染在不斷增加,特別是一些毒力較弱的機會致病菌增加幅度較大,尤其克雷伯氏菌引起人和動物疾病的報導在迅速增多,如家兔的腸炎、肺炎,雛雞腹瀉,綿羊的傳染性口炎,大熊貓的腹瀉、肝炎,豬腹瀉,貂肺炎和豚鼠肺炎等。在人醫方面,克雷伯氏菌引起的感染已上升到僅次於綠膿桿菌,居革蘭氏陰性菌感染的第二位,死亡率可高達60%。人患克雷伯氏菌肺炎,較一般肺炎病情重,對一般肺炎常用的首選藥物青黴素無效。因此,隨著近年來環境的變化,克雷伯氏菌作為人畜共患病的病原,應引起有關部門的足夠重視。
相關條目
肺原性心臟病、大腸桿菌感染、利斯特氏菌病、布魯斯氏菌病、病毒性出血熱、細菌性食物中毒、沙門氏菌病、假單胞菌感染、單純皰疹病毒感染、菌質體感染、葡萄球菌感染、鏈球菌感染、衣原體感染、克雷伯氏菌感染、腺病毒感染、非典型分枝桿菌病、非典型分枝桿菌病、中耳癌、血管運動性鼻炎、急性心肌梗死、腦中風、原發性肺動脈高壓、侵蝕性葡萄胎、分泌性中耳炎、先天性後鼻孔閉鎖、鼻竇囊腫、鼻中隔穿孔、喉阻塞、鏈球菌性咽炎、慢性咽炎、噪聲性耳聾、鼻癤、先生性耳前瘺管、耵聹栓塞、阻塞性睡眠呼吸暫停綜合徵、腺樣體肥大、病毒性心肌炎、病毒性腦膜炎、病毒性皰疹、過敏性哮喘、過敏性結膜炎、佝僂病、甲狀腺機能亢進、帕金森病、老年性白內障、胰腺炎、腎衰竭、視網膜脫離、靜脈炎、骨髓炎、尿道狹窄。
